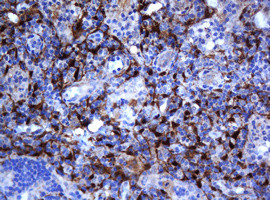
SELENBP1 Antibody in Immunohistochemistry (Paraffin) (IHC (P))

Search
OriGene
SELENBP1 Monoclonal Antibody (OTI3H1), TrueMAB™
{{$productOrderCtrl.translations['antibody.pdp.commerceCard.promotion.promotions']}}
{{$productOrderCtrl.translations['antibody.pdp.commerceCard.promotion.viewpromo']}}
{{$productOrderCtrl.translations['antibody.pdp.commerceCard.promotion.promocode']}}: {{promo.promoCode}} {{promo.promoTitle}} {{promo.promoDescription}}. {{$productOrderCtrl.translations['antibody.pdp.commerceCard.promotion.learnmore']}}
产品信息
TA504701
种属反应
宿主/亚型
分类
类型
克隆号
抗原
偶联物
形式
浓度
纯化类型
保存液
内含物
保存条件
运输条件
靶标信息
Selenium is an essential trace element that confers tolerance to toxicity arising through exposure to heavy metals or other reactive xenobiotics. Selenium exhibits potent anticarcinogenic properties, and deficiency of selenium may cause certain neurologic diseases. Both effects are attributed to selenium-binding proteins. Selenium binding protein 1 is down-regulated in lung adenocarcinoma, colorectal cander and ovarian cancer. It is two-fold upregulated in the brains of patients suffering from schizophrenia, and is therefore a biomarker for this disease.
仅用于科研。不用于诊断过程。未经明确授权不得转售。
篇参考文献 (0)
生物信息学
蛋白别名: 56 kDa selenium-binding protein; epididymis secretory sperm binding protein Li 134P; FLJ13813; hSP56; Lp 56; Methanethiol oxidase; MTO; SBP 1; SBP1; SBP56; Selen bp2; SELENBP 1; Selenbp 2; Selenium-binding protein 1; SELNBP1; SP 56; SP56
基因别名: HEL-S-134P; hSBP; Lp56; LPSB; SBP; SBP56; SELENBP1; SP56
UniProt ID: (Human) Q13228, (Mouse) P17563
Entrez Gene ID: (Human) 8991, (Mouse) 20341